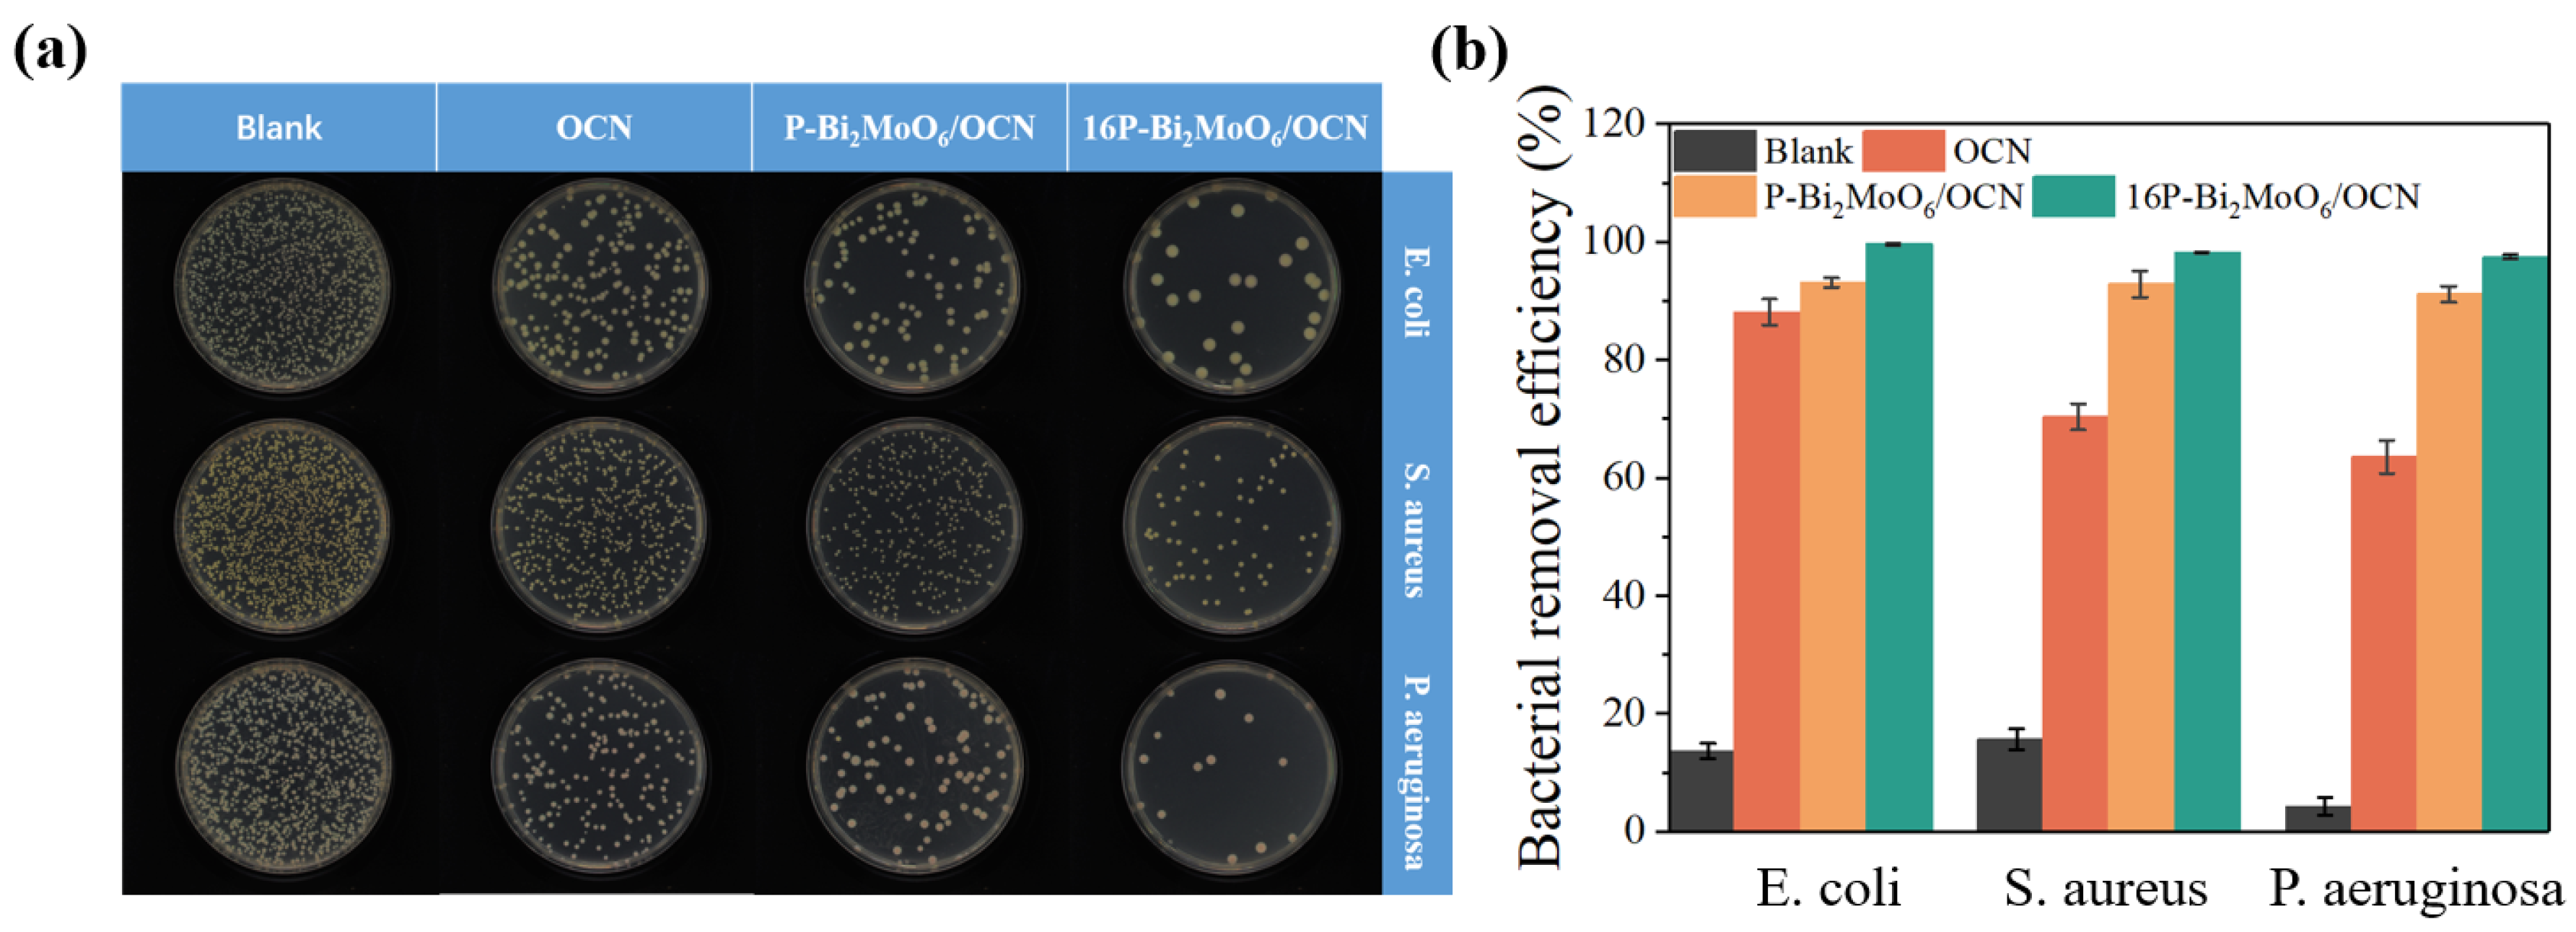
Nanomaterials 15 00834 g009

Optimized Construction of Highly Efficient P-Bi2MoO6/g-C3N4 Photocatalytic Bactericide: Based on Source Material and Synthesis Process
Abstract
1. Introduction
2. Experimental Section
2.1. Preparation of OCN
2.2. Preparation of Three Types of Nanostructured Flower-like Bi2MoO6 Particles
2.3. Preparation of Doped-Bi2MoO6/g-C3N4 Heterojunction
2.4. Characterization of the Materials
2.5. Photocatalytic Degradation Performance
2.6. Photocatalytic Antibacterial Performance
2.7. Photoelectrochemical (PEC) Performance
3. Results and Discussion
3.1. Analyses of Structure and Surface States
3.2. Optical Absorption Property Analysis
3.3. Photo-Generated Free Radical Analysis
4. Conclusions
- Firstly, by comparing the composite of Bi2MoO6 with different doping elements grown on the surface of OCN under the same conditions, it was found that after compounding, the OCN structure collapsed and shrunk into small, interlaced g-C3N4 nanosheets, and the structure was destroyed, which increased the s-triazine structure, but the photocatalytic performance was low and brought disadvantages.
- Furthermore, it is worth noting that in Bi2MoO6 prepared from different molybdenum sources, compared with OCN/P or Na or N doped Bi2MoO6, it is found that the collapsed P-Bi2MoO6/OCN still shows further improved performance compared with Na-Bi2MoO6/OCN and N-Bi2MoO6/OCN, which is significantly higher than any other system. This is because P doping brings more lattice defects and active sites, which helps to promote the separation of photogenerated carriers and the adsorption and activation of reactants. Due to the introduction of abundant Lewis acid sites and other highly active reaction sites by phosphomolybdate, it interacts with OCN of strong Lewis base to effectively promote the generation of superoxide anion radicals by photogenerated electrons. Therefore, it effectively compensates for the unfavorable factors caused by the structural damage of OCN and further improves the photocatalytic activity of the P-Bi2MoO6/g-C3N4 system. In contrast, although the heterojunction of Na- and N-doped Bi2MoO6 prepared from sodium molybdate and ammonium molybdate as molybdenum sources with the shrunken OCN can effectively suppress the recombination of photogenerated carriers, it still reduces the photocatalytic performance due to the inability to strongly compensate for the reduction of active sites.
- Finally, in order to further optimize, the P doping content in P-Bi2MoO6/OCN was increased. The etching effect of phosphoric acid increased the specific surface area of the material, promoted more Bi vacancies and was also accompanied by more metal Bi and Bi oxide precipitation surface, which promoted the charge transfer efficiency. At the same time, the proportion of N atom distribution in OCN was induced and regulated, and more basic sites were obtained. These factors further improve the photocatalytic performance of P-Bi2MoO6/OCN.
Author Contributions
Funding
Data Availability Statement
Conflicts of Interest
References
- Thangudu, S.; Su, C.H. Review of Light Activated Antibacterial Nanomaterials in the Second Biological Window. J. Nanobiotechnol. 2025, 23, 293. [Google Scholar] [CrossRef] [PubMed]
- Malik, S.; Muhammad, K.; Waheed, Y. Emerging Applications of Nanotechnology in Healthcare and Medicine. Molecules 2023, 28, 6624. [Google Scholar] [CrossRef]
- Khan, S.; Noor, T.; Iqbal, N.; Yaqoob, L. Photocatalytic Dye Degradation from Textile Wastewater: A Review. ACS Omega 2024, 9, 21751–21767. [Google Scholar] [CrossRef]
- Jiang, Z.; Long, Q.; Cheng, B.; He, R.; Wang, L. 3D Ordered Macroporous Sulfur-Doped g-C3N4/TiO2 S-Scheme Photocatalysts for Efficient H2O2 Production in Pure Water. J. Mater. Sci. Technol. 2023, 162, 1–10. [Google Scholar] [CrossRef]
- Wang, J.; Wang, S. A Critical Review on Graphitic Carbon Nitride (g-C3N4)-Based Materials: Preparation, Modification and Environmental Application. Coord. Chem. Rev. 2022, 453, 214338. [Google Scholar] [CrossRef]
- Yao, T.; Wang, H.; Qin, Y.; Shi, J.W.; Cheng, Y. Enhancing Pseudocapacitive Behavior of MOF-Derived TiO2-X@Carbon Nanocubes via Mo-Doping for High-Performance Sodium-Ion Capacitors. Compos. Part B Eng. 2023, 253, 110557. [Google Scholar] [CrossRef]
- Murali, G.; Reddy Modigunta, J.K.; Park, Y.H.; Lee, J.H.; Rawal, J.; Lee, S.Y.; In, I.; Park, S.J. A Review on MXene Synthesis, Stability, and Photocatalytic Applications. ACS Nano 2022, 16, 13370–13429. [Google Scholar] [CrossRef]
- Ding, J.; He, D.; Du, P.; Wu, J.; Hu, Q.; Chen, Q.; Jiao, X. Design Photocatalysts to Boost Carrier Dynamics in Plastics Photoconversion into Fuels. ACS Appl. Mater. Interfaces 2024, 16, 35865–35873. [Google Scholar] [CrossRef]
- Li, Z.; Liu, F.; Lu, Y.; Hu, J.; Feng, J.; Shang, H.; Sun, B.; Jiang, W. Molecular Design of Perylene Diimide Derivatives for Photocatalysis. ACS Catal. 2025, 15, 1829–1840. [Google Scholar] [CrossRef]
- Sun, Y.D.; Zeng, C.; Zhang, X.; Zhang, Z.Q.; Yang, B.; Guo, S.Q. Tendencies of Alloyed Engineering in BiOX-Based Photocatalysts: A State-of-the-Art Review. Rare Met. 2024, 43, 1488–1512. [Google Scholar] [CrossRef]
- Zhang, Y.; Chen, Z.; Li, J.; Lu, Z.; Wang, X. Self-Assembled Synthesis of Oxygen-Doped g-C3N4 Nanotubes in Enhancement of Visible-Light Photocatalytic Hydrogen. J. Energy Chem. 2021, 54, 36–44. [Google Scholar] [CrossRef]
- Zhu, X.; Luo, J.; Dong, Z.; Li, Z.; Wu, Y.; Cheng, Z.; Cao, X.; Wang, Y.; Liu, Y.; Zhang, Z. Synthesis of High Crystallinity G-C3N4 Hollow Spheres for Efficient Photocatalytic Removal of U(VI) under Visible Light. Sep. Purif. Technol. 2023, 324, 124235. [Google Scholar] [CrossRef]
- Li, D.; Wen, C.; Huang, J.; Zhong, J.; Chen, P.; Liu, H.; Wang, Z.; Liu, Y.; Lv, W.; Liu, G. High-Efficiency Ultrathin Porous Phosphorus-Doped Graphitic Carbon Nitride Nanosheet Photocatalyst for Energy Production and Environmental Remediation. Appl. Catal. B-Environ. Energy 2022, 307, 121099. [Google Scholar] [CrossRef]
- Liu, C.; Dai, H.; Tan, C.; Pan, Q.; Hu, F.; Peng, X. Photo-Fenton Degradation of Tetracycline over Z-Scheme Fe-g-C3N4/Bi2WO6 Heterojunctions: Mechanism Insight, Degradation Pathways and DFT Calculation. Appl. Catal. B-Environ. Energy 2022, 310, 121326. [Google Scholar] [CrossRef]
- Xie, Q.; He, W.; Liu, S.; Li, C.; Zhang, J.; Wong, P.K. Bifunctional S-Scheme g-C3N4/Bi/BiVO4 Hybrid Photocatalysts toward Artificial Carbon Cycling. Chin. J. Catal. 2020, 41, 140–153. [Google Scholar] [CrossRef]
- Liu, X.; Gu, S.; Zhao, Y.; Zhou, G.; Li, W. BiVO4, Bi2WO6 and Bi2MoO6 Photocatalysis: A Brief Review. J. Mater. Sci. Technol. 2020, 56, 45–68. [Google Scholar] [CrossRef]
- Di, G.; Zhu, Z.; Zhang, H.; Qiu, Y.; Yin, D.; Crittenden, J. Simultaneous Sulfamethazine Oxidation and Bromate Reduction by Pd-Mediated Z-Scheme Bi2MoO6/g-C3N4 Photocatalysts: Synergetic Mechanism and Degradative Pathway. Chem. Eng. J. 2020, 401, 126061. [Google Scholar] [CrossRef]
- Li, Q.; Zhao, W.; Zhai, Z.; Ren, K.; Wang, T.; Guan, H.; Shi, H. 2D/2D Bi2MoO6/g-C3N4 S-Scheme Heterojunction Photocatalyst with Enhanced Visible-Light Activity by Au Loading. J. Mater. Sci. Technol. 2020, 56, 216–226. [Google Scholar] [CrossRef]
- Huang, J.; Qiu, J.; Yang, Y.; Li, B.; Wang, L.; Cheng, H.M.; Liu, G. Interface Regulation of Bi3TiNbO9/Rh Photocatalysts by Introducing Ultrathin Heterolayer to Enhance Overall Water Splitting. Adv. Funct. Mater. 2024, 34, 2402711. [Google Scholar] [CrossRef]
- Yu, H.; Jiang, L.; Wang, H.; Huang, B.; Yuan, X.; Huang, J.; Zhang, J.; Zeng, G. Modulation of Bi2MoO6-Based Materials for Photocatalytic Water Splitting and Environmental Application: A Critical Review. Small 2019, 15, 1901008. [Google Scholar] [CrossRef]
- Lyu, M.; Wang, C.; Rong, Y.; Wei, J.; Yang, Y.; Liu, Y.; Wei, G.; Zhang, Q.; Wang, C.; Xiu, J. Advances in Modification of Bi2MoO6 and Its Photocatalysis: A Review. J. Alloys Compd. 2024, 982, 173759. [Google Scholar] [CrossRef]
- Chang, X.; Liu, J.; Guo, Z.; Cheng, Y.; Yan, Q.; Li, Y.Y. Enhanced Photocatalytic Performance of Bi2MoO6 via Strain Engineering through Collaborative Optimization of Indium Doping and Oxygen Vacancies. Appl. Catal. B-Environ. Energy 2024, 349, 123858. [Google Scholar] [CrossRef]
- Li, J.; Chen, C.; Bai, J.; Jin, Y.; Guo, C. Boosting of the Piezoelectric Photocatalytic Performance of Bi2MoO6 by Fe3+ Doping and Construction S-Scheme Heterojunction Using WO3. J. Colloid Interface Sci. 2025, 683, 574–584. [Google Scholar] [CrossRef]
- Heo, J.; Roh, Y.; Shin, K.; Lee, C.; Wang, C.; Kim, H.T. Versatile Zn Hosting Lewis-Basic Interfacial Layer for High-Performant Zn Reversibility in Aqueous Zn Ion Battery. Energy Storage Mater. 2024, 71, 103580. [Google Scholar] [CrossRef]
- Wang, Q.; Zhang, Y.; Li, J.; Liu, N.; Jiao, Y.; Jiao, Z. Construction of Electron Transport Channels in Type-I Heterostructures of Bi2MoO6/BiVO4/g-C3N4 for Improved Charge Carriers Separation Efficiency. J. Colloid Interface Sci. 2020, 567, 145–153. [Google Scholar] [CrossRef]
- Vesali-Kermani, E.; Habibi-Yangjeh, A.; Diarmand-Khalilabad, H.; Ghosh, S. Nitrogen Photofixation Ability of G-C3N4 Nanosheets/Bi2MoO6 Heterojunction Photocatalyst under Visible-Light Illumination. J. Colloid Interface Sci. 2020, 563, 81–91. [Google Scholar] [CrossRef]
- Ma, D.; Wu, J.; Gao, M.; Xin, Y.; Chai, C. Enhanced Debromination and Degradation of 2,4-Dibromophenol by an Z-Scheme Bi2MoO6/CNTs/g-C3N4 Visible Light Photocatalyst. Chem. Eng. J. 2017, 316, 461–470. [Google Scholar] [CrossRef]
- Wang, Y.; Xing, Z.; Yang, Y.; Kong, W.; Wu, C.; Peng, H.; Li, Z.; Xie, Y.; Zhou, W. Oxygen-Defective Bi2MoO6/g-C3N4 Hollow Tubulars S-Scheme Heterojunctions toward Optimized Photocatalytic Performance. J. Colloid Interface Sci. 2024, 653, 1566–1576. [Google Scholar] [CrossRef]
- Fan, Y.; Xiong, J.; Cai, Y.; Huang, S.; Liang, Y.; Jiang, S.; Chen, G. Bi2MoO6/g-C3N4 S-Type Heterojunction with Oxygen Vacancies for Enhanced Removal of Ciprofloxacin: Investigation of Degradation Efficiency and Mechanism. J. Water Process Eng. 2025, 71, 107157. [Google Scholar] [CrossRef]
- Yu, H.; Shi, R.; Zhao, Y.; Bian, T.; Zhao, Y.; Zhou, C.; Waterhouse, G.I.N.; Wu, L.Z.; Tung, C.H.; Zhang, T. Alkali-Assisted Synthesis of Nitrogen Deficient Graphitic Carbon Nitride with Tunable Band Structures for Efficient Visible-Light-Driven Hydrogen Evolution. Adv. Mater. 2017, 29, 1605148. [Google Scholar] [CrossRef]
- He, W.; Wei, Y.; Xiong, J.; Tang, Z.; Song, W.; Liu, J.; Zhao, Z. Insight into Reaction Pathways of CO2 Photoreduction into CH4 over Hollow Microsphere Bi2MoO6-Supported Au Catalysts. Chem. Eng. J. 2022, 433, 133540. [Google Scholar] [CrossRef]
- Li, J.; Yin, Y.; Liu, E.; Ma, Y.; Wan, J.; Fan, J.; Hu, X. In Situ Growing Bi2MoO6 on G-C3N4 Nanosheets with Enhanced Photocatalytic Hydrogen Evolution and Disinfection of Bacteria under Visible Light Irradiation. J. Hazard. Mater. 2017, 321, 183–192. [Google Scholar] [CrossRef] [PubMed]
- Li, C.; Sun, Z.; Zhang, W.; Yu, C.; Zheng, S. Highly Efficient G-C3N4/TiO2/Kaolinite Composite with Novel Three-Dimensional Structure and Enhanced Visible Light Responding Ability towards Ciprofloxacin and S. Aureus. Appl. Catal. B-Environ. Energy 2018, 220, 272–282. [Google Scholar] [CrossRef]
- Xu, C.; Wang, Y.; Ma, X.; Wang, X.; Yang, Y.; Zhang, Q. High-Efficient Removal of Tebuconazole from Aqueous Solutions Using P-Doped Corn Straw Biochar: Performance, Mechanism and Application. Bioresour. Technol. 2024, 412, 131387. [Google Scholar] [CrossRef]
- Yussuf, N.M.; Ismail, A.F.; Rahmat, M.A.; Mohamed, N.A. Electrosorption-Driven Selective Thorium Removal from Radioactive Wastewater with Phosphate—Incorporated g-C3N4 Electrode. J. Environ. Chem. Eng. 2024, 12, 113440. [Google Scholar] [CrossRef]
- Luo, W.; Li, Y.; Wang, J.; Liu, J.; Zhang, N.; Zhao, M.; Wu, J.; Zhou, W.; Wang, L. Asymmetric Structure Engineering of Polymeric Carbon Nitride for Visible-Light-Driven Reduction Reactions. Nano Energy 2021, 87, 106168. [Google Scholar] [CrossRef]
- Yang, J.; Xie, T.; Mei, Y.; Chen, J.; Sun, H.; Feng, S.; Zhang, Y.; Zhao, Y.; Wang, J.; Li, X.; et al. High-Efficiency V-Mediated Bi2MoO6 Photocatalyst for PMS Activation: Modulation of Energy Band Structure and Enhancement of Surface Reaction. Appl. Catal. B-Environ. Energy 2023, 339, 123149. [Google Scholar] [CrossRef]
- Faizan, M.; Li, Y.; Wang, X.; Song, P.; Zhang, R.; Liu, R. Rare Earth Metal Based DES Assisted the VPO Synthesis for N-Butane Selective Oxidation toward Maleic Anhydride. Green Energy Environ. 2023, 8, 1737–1752. [Google Scholar] [CrossRef]
- Sahar, J.; Farooq, M.; Ramli, A.; Naeem, A.; Khattak, N.S.; Ghazi, Z.A. Highly Efficient Heteropoly Acid Decorated SnO2@Co-ZIF Nanocatalyst for Sustainable Biodiesel Production from Nannorrhops Ritchiana Seeds Oil. Renew. Energy 2022, 198, 306–318. [Google Scholar] [CrossRef]
- Liu, Y.; Guo, J.-g.; Wang, Y.; Hao, Y.-j.; Liu, R.-h.; Li, F.-t. One-Step Synthesis of Defected Bi2Al4O9/β-Bi2O3 Heterojunctions for Photocatalytic Reduction of CO2 to CO. Green Energy Environ. 2021, 6, 244–252. [Google Scholar] [CrossRef]
- Wong, K.T.; Brigljević, B.; Lee, J.H.; Yoon, S.Y.; Jang, S.B.; Choong, C.E.; Nah, I.; Kim, H.; Roh, H.S.; Kwak, S.K.; et al. Highly Exposed -NH2 Edge on Fragmented g-C3N4 Framework with Integrated Molybdenum Atoms for Catalytic CO2 Cycloaddition: DFT and Techno-Economic Assessment. Small 2023, 19, 2204336. [Google Scholar] [CrossRef] [PubMed]
- Ding, L.; Li, M.; Zhao, Y.; Zhang, H.; Shang, J.; Zhong, J.; Sheng, H.; Chen, C.; Zhao, J. The Vital Role of Surface Brönsted Acid/Base Sites for the Photocatalytic Formation of Free ·OH Radicals. Appl. Catal. B-Environ. Energy 2020, 266, 118634. [Google Scholar] [CrossRef]
- Chen, W.; Duan, G.R.; Liu, T.Y.; Chen, S.M.; Liu, X.H. Fabrication of Bi2MoO6 Nanoplates Hybridized with G-C3N4 Nanosheets as Highly Efficient Visible Light Responsive Heterojunction Photocatalysts for Rhodamine B Degradation. Mater. Sci. Semicond. Process. 2015, 35, 45–54. [Google Scholar] [CrossRef]
- Mao, S.; Zhao, P.; Wu, Y.; Liu, C.; Xia, M.; Wang, F. Promoting Charge Migration of Co(OH)2/g-C3N4 by Hydroxylation for Improved PMS Activation: Catalyst Design, DFT Calculation and Mechanism Analysis. Chem. Eng. J. 2023, 451, 138503. [Google Scholar] [CrossRef]
- Dong, P.; Zhang, A.; Cheng, T.; Pan, J.; Song, J.; Zhang, L.; Guan, R.; Xi, X.; Zhang, J. 2D/2D S-Scheme Heterojunction with a Covalent Organic Framework and g-C3N4 Nanosheets for Highly Efficient Photocatalytic H2 Evolution. Chin. J. Catal. 2022, 43, 2592–2605. [Google Scholar] [CrossRef]
- Yang, X.; Qian, F.; Zou, G.; Li, M.; Lu, J.; Li, Y.; Bao, M. Facile Fabrication of Acidified G-C3N4/g-C3N4 Hybrids with Enhanced Photocatalysis Performance under Visible Light Irradiation. Appl. Catal. B-Environ. Energy 2016, 193, 22–35. [Google Scholar] [CrossRef]
- Xu, T.; Xia, Z.; Li, H.; Niu, P.; Wang, S.; Li, L. Constructing Crystalline G-C3N4/g-C3N4−xSx Isotype Heterostructure for Efficient Photocatalytic and Piezocatalytic Performances. Energy Environ. Mater. 2022, 6, e12306. [Google Scholar] [CrossRef]
- Schiros, T.; Nordlund, D.; Pálová, L.; Prezzi, D.; Zhao, L.; Kim, K.S.; Wurstbauer, U.; Gutiérrez, C.; Delongchamp, D.; Jaye, C.; et al. Connecting Dopant Bond Type with Electronic Structure in N-Doped Graphene. Nano Lett. 2012, 12, 4025–4031. [Google Scholar] [CrossRef]
- Qian, Y.; Lu, T.; Liu, K.; Lu, G.; Xiao, J.; Zeng, X. Nickel Metal Nanoparticles Encapsulated by N-Doped Carbon Nanotubes Derived from g-C3N4 for Efficient Electrocatalytic Oxygen Reduction Reaction. Diam. Relat. Mater. 2025, 154, 112220. [Google Scholar] [CrossRef]
- Tao, K.Y.; Yuan, K.; Yang, W.; Zhong, D.C.; Lu, T.B. A Template Co-Pyrolysis Strategy towards the Increase of Amino/Imino Content within g-C3N4 for Efficient CO2 Photoreduction. Chem. Eng. J. 2023, 455, 140630. [Google Scholar] [CrossRef]
- Zhang, L.; Wang, Z.; Hu, C.; Shi, B. Enhanced Photocatalytic Performance by the Synergy of Bi Vacancies and Bi0 in Bi0-Bi2-δMoO6. Appl. Catal. B-Environ. Energy 2019, 257, 117785. [Google Scholar] [CrossRef]
- Kang, Z.; Lin, E.; Qin, N.; Wu, J.; Bao, D. Bismuth Vacancy-Mediated Quantum Dot Precipitation to Trigger Efficient Piezocatalytic Activity of Bi2WO6 Nanosheets. ACS Appl. Mater. Interfaces 2022, 14, 11375–11387. [Google Scholar] [CrossRef] [PubMed]
- Li, Y.; Xu, K.; Hu, H.; Jia, L.; Zhang, Y.; Zhuoga, C.; Yang, P.; Tan, X.; Guo, W.; Hao, W.; et al. Bi Vacancy Simultaneous Manipulation of Bulk Adsorption and Carrier Utilization to Replenish the Mechanism of Cr(VI) Photoreduction at Universal PH. Chem. Eng. J. 2022, 450, 138106. [Google Scholar] [CrossRef]
- Li, N.; Gao, H.; Wang, X.; Zhao, S.; Lv, D.; Yang, G.; Gao, X.; Fan, H.; Gao, Y.; Ge, L. Novel Indirect Z-Scheme g-C3N4/Bi2MoO6/Bi Hollow Microsphere Heterojunctions with SPR-Promoted Visible Absorption and Highly Enhanced Photocatalytic Performance. Chin. J. Catal. 2020, 41, 426–434. [Google Scholar] [CrossRef]
- Chen, X.; Sun, H.; Kuo, D.H.; Abdeta, A.B.; Zelekew, O.A.; Guo, Y.; Zhang, J.; Yuan, Z.; Lin, J. Spherical Nanoflower-like Bimetallic (Mo,Ni)(S,O)3-x Sulfo-Oxide Catalysts for Efficient Hydrogen Evolution under Visible Light. Appl. Catal. B-Environ. Energy 2021, 287, 119992. [Google Scholar] [CrossRef]
- Zhang, L.; Hao, X.; Wang, Y.; Jin, Z.; Ma, Q. Construction Strategy of Mo-S@Mo-P Heterojunction Formed with in-Situ Phosphating Mo-S Nanospheres toward Efficient Photocatalytic Hydrogen Production. Chem. Eng. J. 2020, 391, 123545. [Google Scholar] [CrossRef]
- Zhou, X.; Wang, T.; Zhang, L.; Che, S.; Liu, H.; Liu, S.; Wang, C.; Su, D.; Teng, Z. Highly Efficient Ag2O/Na-g-C3N4 Heterojunction for Photocatalytic Desulfurization of Thiophene in Fuel under Ambient Air Conditions. Appl. Catal. B-Environ. Energy 2022, 316, 121614. [Google Scholar] [CrossRef]
- Hu, K.; Li, R.; Ye, C.; Wang, A.; Wei, W.; Hu, D.; Qiu, R.; Yan, K. Facile Synthesis of Z-Scheme Composite of TiO2 Nanorod/g-C3N4 Nanosheet Efficient for Photocatalytic Degradation of Ciprofloxacin. J. Clean. Prod. 2020, 253, 120055. [Google Scholar] [CrossRef]
- He, W.; Wei, Y.; Xiong, J.; Tang, Z.; Wang, Y.; Wang, X.; Xu, H.; Zhang, X.; Yu, X.; Zhao, Z.; et al. Variable Valence Mo5+/Mo6+ Ionic Bridge in Hollow Spherical g-C3N4/Bi2MoO6 Catalysts for Promoting Selective Visible Light-Driven CO2 Photoreduction into CO. J. Energy Chem. 2023, 80, 361–372. [Google Scholar] [CrossRef]
- Blowey, P.J.; Blowey, P.J.; Sohail, B.; Rochford, L.A.; Lafosse, T.; Duncan, D.A.; Ryan, P.T.P.; Ryan, P.T.P.; Warr, D.A.; Lee, T.L.; et al. Alkali Doping Leads to Charge-Transfer Salt Formation in a Two-Dimensional Metal-Organic Framework. ACS Nano 2020, 14, 7475–7483. [Google Scholar] [CrossRef]
- Deng, X.; Chen, P.; Cui, R.; Gong, X.; Li, X.; Wang, X.; Deng, C. Synergistic Polarity Interaction and Structural Reconstruction in Bi2MoO6/C3N4 Heterojunction for Enhancing Piezo-Photocatalytic Nitrogen Oxidation to Nitric Acid. Appl. Catal. B-Environ. Energy 2024, 351, 123977. [Google Scholar] [CrossRef]
- Ma, T.; Li, R.; Huang, Y.C.; Lu, Y.; Guo, L.; Niu, M.; Huang, X.; Soomro, R.A.; Ren, J.; Wang, Q.; et al. Interfacial Chemical-Bonded MoS2/In-Bi2MoO6 Heterostructure for Enhanced Photocatalytic Nitrogen-to-Ammonia Conversion. ACS Catal. 2024, 14, 6292–6304. [Google Scholar] [CrossRef]
- He, J.; Lin, J.; Zhang, Y.; Hu, Y.; Huang, Q.; Zhou, G.; Li, W.; Hu, J.; Hu, N.; Yang, Z. Interfacial Mo-S Bond-Reinforced Hierarchical S-Scheme Heterostructure of Bi2MoO6@ZnIn2S4 for Highly-Selective and Efficient CO2 Photoreduction into CO. Chem. Eng. J. 2024, 480, 148036. [Google Scholar] [CrossRef]
- Yan, T.; Liu, Q.; Wang, S.; Xu, G.; Wu, M.; Chen, J.; Li, J. Promoter Rather than Inhibitor: Phosphorus Incorporation Accelerates the Activity of V2O5-WO3/TiO2 Catalyst for Selective Catalytic Reduction of NOx by NH3. ACS Catal. 2020, 10, 2747–2753. [Google Scholar] [CrossRef]
- Yang, Z.; Fu, X.; Ma, D.; Wang, Y.; Peng, L.; Shi, J.; Sun, J.; Gan, X.; Deng, Y.; Yang, W. Growth Factor-Decorated Ti3C2 MXene/MoS2 2D Bio-Heterojunctions with Quad-Channel Photonic Disinfection for Effective Regeneration of Bacteria-Invaded Cutaneous Tissue. Small 2021, 17, 2103993. [Google Scholar] [CrossRef]
- Tian, Y.; Zhou, M.; Pan, Y.; Du, X.; Wang, Q. MoS2 as Highly Efficient Co-Catalyst Enhancing the Performance of Fe0 Based Electro-Fenton Process in Degradation of Sulfamethazine: Approach and Mechanism. Chem. Eng. J. 2021, 403, 126361. [Google Scholar] [CrossRef]
- Zhu, L.; Cheng, P.; Xiao, Z.; Lu, C.; Li, B.; Jiang, X.; Shen, Z.; Qian, N.; Zhong, W.; He, Y. Incorporation of Phenolic Skeleton into Imidazolium Ionic Polymers as Recyclable Catalysts for Efficient Fixation of CO2 into Cyclic Carbonates. Chem. Eng. J. 2024, 481, 148359. [Google Scholar] [CrossRef]
- Ma, L.; Gao, Y.; Wei, B.; Huang, L.; Zhang, N.; Weng, Q.; Zhang, L.; Liu, S.F.; Jiang, R. Visible-Light Photocatalytic H2O2 Production Boosted by Frustrated Lewis Pairs in Defected Polymeric Carbon Nitride Nanosheets. ACS Catal. 2024, 14, 2775–2786. [Google Scholar] [CrossRef]

| Sample | a (Å) | b (Å) | c (Å) | Vol (Å3) |
|---|---|---|---|---|
| P-Bi2MoO6 | 5.55 | 16.23 | 5.44 | 490.70 |
| Na-Bi2MoO6 | 5.50 | 16.21 | 5.48 | 489.11 |
| N-Bi2MoO6 | 5.53 | 16.14 | 5.49 | 490.38 |
| Sample | SBET (m2/g) | Pore Volume (cm3/g) | Average Pore Radius (nm) |
|---|---|---|---|
| OCN | 94.78 | 0.16 | 12.48 |
| P-Bi2MoO6 | 46.89 | 0.10 | 4.54 |
| P-Bi2MoO6/OCN | 85.54 | 0.17 | 10.69 |
| 16P-Bi2MoO6/OCN | 97.10 | 0.19 | 10.65 |
| Sample | Quantity of Weak and Medium Acid Sites (mmol/g) | Quantity of Strong Acid Sites (mmol/g) | Total Quantity (mmol/g) |
|---|---|---|---|
| P-Bi2MoO6/OCN | 0.18254 | 0.78667 | 0.96921 |
| 16P-Bi2MoO6/OCN | 0.12939 | 0.8423 | 0.97169 |
| Sample | Quantity of Weak and Medium Base Sites (mmol/g) | Quantity of Strong Base Sites (mmol/g) | Total Quantity (mmol/g) |
|---|---|---|---|
| P-Bi2MoO6/OCN | 0.01025 | 9.34322 | 9.35347 |
| 16P-Bi2MoO6/OCN | 0.00197 | 16.48958 | 16.49155 |
| Sample | C-N=C | N-(C)3 | NHx | C-N=C/N-(C)3 | C/N |
|---|---|---|---|---|---|
| OCN | 76.44% | 9.99% | 6.28% | 7.65 | 0.45 |
| P-Bi2MoO6/OCN | 80.81% | 3.05% | 8.05% | 26.50 | 0.46 |
| 16P-Bi2MoO6/OCN | 57.25% | 22.11% | 12.45% | 2.59 | 0.57 |
| Sample | Bi/Mo | O-Bi/O-Mo | Mo4+/Mo6+ |
|---|---|---|---|
| P-Bi2MoO6 | 8.13 | 1.04 | 24.01 |
| Na-Bi2MoO6 | 7.10 | 3.52 | 30.79 |
| N-Bi2MoO6 | 6.75 | 2.98 | 27.18 |
| P-Bi2MoO6/OCN | 6.94 | 3.52 | 41.12 |
| 16P-Bi2MoO6/OCN | 9.52 | 2.72 | 20.79 |
Disclaimer/Publisher’s Note: The statements, opinions and data contained in all publications are solely those of the individual author(s) and contributor(s) and not of MDPI and/or the editor(s). MDPI and/or the editor(s) disclaim responsibility for any injury to people or property resulting from any ideas, methods, instructions or products referred to in the content. |
© 2025 by the authors. Licensee MDPI, Basel, Switzerland. This article is an open access article distributed under the terms and conditions of the Creative Commons Attribution (CC BY) license (https://creativecommons.org/licenses/by/4.0/).
Share and Cite
Xue, L.; Zhang, J.; Sun, M.; Zhang, H.; Wang, K.; Wang, D.; Zhang, R. Optimized Construction of Highly Efficient P-Bi2MoO6/g-C3N4 Photocatalytic Bactericide: Based on Source Material and Synthesis Process. Nanomaterials 2025, 15, 834. https://doi.org/10.3390/nano15110834
Xue L, Zhang J, Sun M, Zhang H, Wang K, Wang D, Zhang R. Optimized Construction of Highly Efficient P-Bi2MoO6/g-C3N4 Photocatalytic Bactericide: Based on Source Material and Synthesis Process. Nanomaterials. 2025; 15(11):834. https://doi.org/10.3390/nano15110834
Chicago/Turabian StyleXue, Leilei, Jie Zhang, Mengmeng Sun, Hui Zhang, Ke Wang, Debao Wang, and Ruiyong Zhang. 2025. "Optimized Construction of Highly Efficient P-Bi2MoO6/g-C3N4 Photocatalytic Bactericide: Based on Source Material and Synthesis Process" Nanomaterials 15, no. 11: 834. https://doi.org/10.3390/nano15110834
APA StyleXue, L., Zhang, J., Sun, M., Zhang, H., Wang, K., Wang, D., & Zhang, R. (2025). Optimized Construction of Highly Efficient P-Bi2MoO6/g-C3N4 Photocatalytic Bactericide: Based on Source Material and Synthesis Process. Nanomaterials, 15(11), 834. https://doi.org/10.3390/nano15110834

